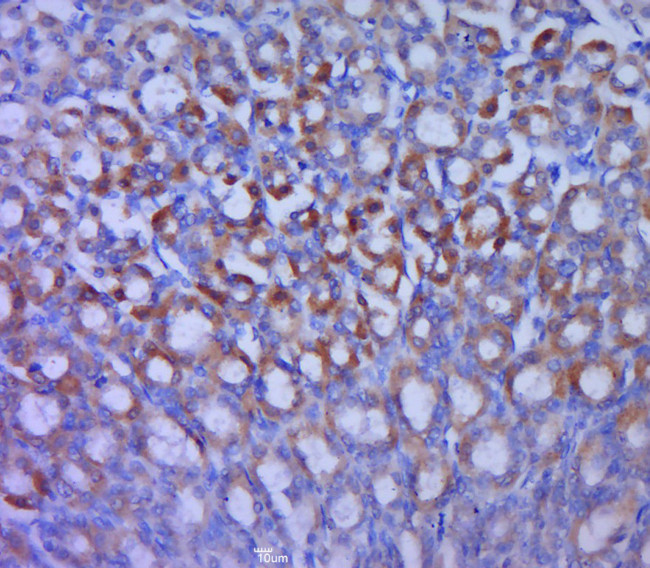
GLUT12 Antibody in Immunohistochemistry (Paraffin) (IHC (P))

Search
Bioss
GLUT12 Polyclonal Antibody
{{$productOrderCtrl.translations['antibody.pdp.commerceCard.promotion.promotions']}}
{{$productOrderCtrl.translations['antibody.pdp.commerceCard.promotion.viewpromo']}}
{{$productOrderCtrl.translations['antibody.pdp.commerceCard.promotion.promocode']}}: {{promo.promoCode}} {{promo.promoTitle}} {{promo.promoDescription}}. {{$productOrderCtrl.translations['antibody.pdp.commerceCard.promotion.learnmore']}}
图: 1 / 2
GLUT12 Antibody (BS-2540R) in IHC (P)


产品信息
BS-2540R
种属反应
宿主/亚型
分类
类型
抗原
偶联物
形式
浓度
规格
纯化类型
保存液
内含物
保存条件
运输条件
靶标信息
Solute carrier family 2, facilitated glucose transporter member 12 is a protein that in humans is encoded by the SLC2A12 gene. SLC2A12 belongs to a family of transporters that catalyze the uptake of sugars through facilitated diffusion. This family of transporters show conservation of 12 transmembrane helices as well as functionally significant amino acid residues.
仅用于科研。不用于诊断过程。未经明确授权不得转售。
篇参考文献 (0)
生物信息学
蛋白别名: facilitated glucose transporter; Glucose transporter type 12; GLUT-12; solute carrier family 2 (facilitated glucose transporter), member 12; Solute carrier family 2, facilitated glucose transporter member 12; solute carrier family 2, member 12; unnamed protein product
基因别名: GLUT-12; GLUT12; GLUT8; SLC2A12
UniProt ID: (Human) Q8TD20, (Mouse) Q8BFW9
Entrez Gene ID: (Human) 154091, (Mouse) 353169, (Rat) 308028